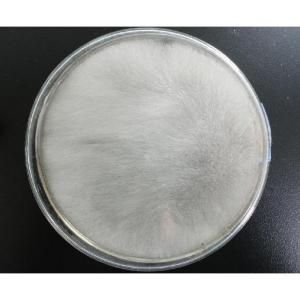
散布毛霉 散布毛霉

相關詞條
-
細菌孢子
下來,當條件適宜時能萌發成菌絲體。毛霉屬中的總狀毛霉(M.rcemosus...,此後卵球生出外壁即成為卵孢子。②接合孢子:接合孢子是接合菌亞門、毛霉...;部分能生存於零下的溫度;部分會散布毒性的化合物, 例如蘇力菌合成 Cry...
簡介 分類 特點 蕨類孢子 -
麵包霉
單細胞,含有多個細胞核,如毛霉、棍霉、梨頭霉的菌絲體。另一類黴菌菌絲體細胞...要是毛霉、棍霉、麴黴等等。毛霉分菌絲、孢子囊柄、孢子囊等部分,孢子囊中有...
防止發霉 霉變原因 -
藻狀菌類
的孢子隨氣流到處散布。有性繁殖產生接合孢子。根霉在自然界分布很廣,分解...等。二、毛霉屬毛霉屬:菌絲體茂盛無隔膜,氣生菌絲亦如白色棉絮,無...頂端有球形孢子囊,內生孢囊孢子。有性生殖亦為接合孢子。毛霉分解澱粉、蛋白質...
海洋真菌 藻狀菌綱 -
藻狀菌綱
,囊壁破裂,釋放的孢子隨氣流到處散布。有性繁殖產生接合孢子。 根霉在自然界...、轉化甾族化合物等。 二、毛霉屬(Mucor):菌絲體茂盛無隔膜,氣生菌絲...。毛霉分解澱粉、蛋白質能力均強,是製作腐乳、豆豉的重要菌種。有的種的生產...
代表植物 小結 相關詞語 參考資料 -
接合菌
。孢子囊成熟後破裂,孢子隨風散布,在適宜條件下再萌髮長成菌絲。在環境不利時期...,少數寄生。主要代表有毛霉屬和根霉屬。接合菌病接合菌病(zygomycosis)由接合菌綱的致病性真菌所致.接合菌綱包括毛霉目和蟲霉目.由...
接合菌亞門 接合菌病 -
中國古代化學史
大量木炭,多處散布著燒過的獸骨和石灰。 人類在使用火的過程中,除了...
中國古代化學史 正文 配圖 相關連線 -
接合菌亞門
產生大量不動的孢子,稱為孢囊孢子。孢子囊成熟後破裂,孢子隨風散布,在適宜...寄生。主要代表有毛霉屬和根霉屬。 亞種分類該亞門下分接合菌綱和毛菌綱2...
簡介 特徵 亞種分類 -
發霉
知道他的生活史。1. 菌絲產生分生孢子2. 散布孢子3. 孢子萌發產生菌絲...細分為毛霉屬、根霉屬、麴黴屬、紅麴黴屬四類。物品發生霉變不僅與環境溫度...
詞語概念 分級別表 生活史 判斷預防